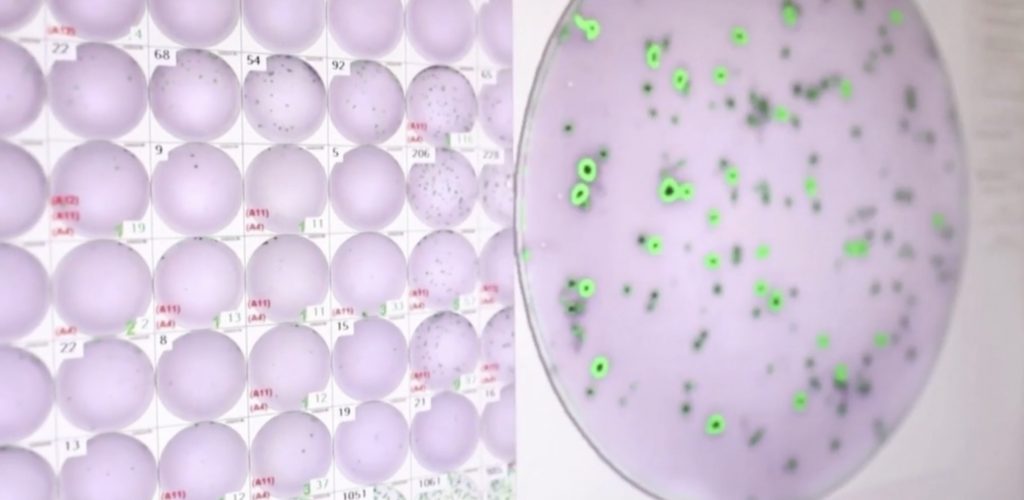
featured

Koronavirüsle mücadelede yeni gündem maddesi, koronavirüsün geçirdiği mutasyonlar. Virüs çoğaldıkça, mutasyona uğrama ihtimali de artıyor. Türkiye’de İngiltere, Güney Afrika ve Brezilya varyantı görülmüştü.
“Ülkemize has varyantların olduğunu da biliyoruz”
Bilim Kurulu üyesi Prof. Dr. Hasan Tezer, Türkiye’ye özgü koronavirüs varyantlarının da tespit edildiğini söyledi.
Tezer, Ülkemize has varyantların olduğunu da biliyoruz. Tabi bunun ne kadar etkileyeceğini şu an bilmiyoruz” dedi.
“Virüsün çoğalma zinciri kırılmalı”
Mutasyonlu virüsün yayılımına ilişkin açıklama yapan Kocaeli Üniversitesi Enfeksiyon Hastalıkları Uzamanı Prof. Dr. Sıla Akhan, “Çoğalma zincirde kırılmadığı için o şekilde çoğalıyor. O yüzden de mesala buradaki varyantlardan, çok çeşit varyantlardan ülkemizde de mutlaka çıkmış ve çıkacaktır da. Bunlardan da kendi içinde daha önem kazananlar ilerleyebilir. Eğer biz bu döngüyü kırmazsak” dedi.
Türkiye’deki mutasyonların boyutunu, yapılacak araştırmalar gösterecek. Uzmanlara göre virüsün çoğalmasının önüne geçildiğinde, mutasyonların riski de önlenebilecek.
Akhan, “O döngünün kırılması gerekiyor. Çünkü bu şekilde bir fırsat bulmuş oluyor ve bunun önüne de geçemeyiz. Ne kadar değişeceğini de öngöremeyiz” açıklamasında bulundu.
“Bunun çoğalarak artacağını biliyoruz”
Mutasyonlu virüs tespit edilen kişilerin izolasyonunun da salgının seyri için önemli olduğunu vurgulayan Akhan, “Bunun çoğalarak artacağını biliyoruz. Çok kısa zamanda İngiltere örneği gibi bir anda hakim ve ana suçlu haline, ana varyant haline gelebileceğini biliyoruz. O yüzden bu açıdan bütünüyle lokalizasyonu ve bölgesel önlemler şu aşamada çok önemli” diye konuştu.
NK/TRT